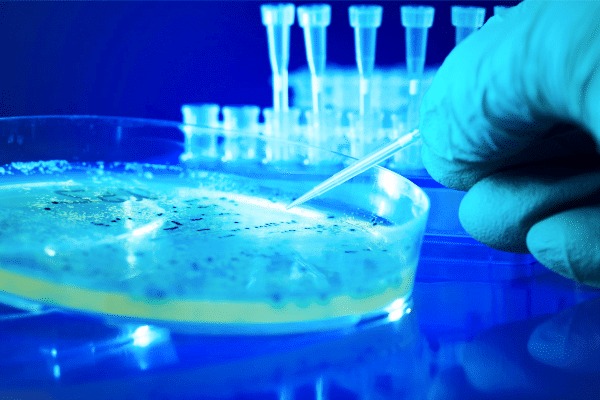
service

SOLICITUD DE EXÁMENES
Complete la solicitud en línea y envíenos los antecedentes del paciente. Nuestro equipo procesará el examen y le entregará un informe confiable para apoyar su diagnóstico.
Solicitar ExámenYa sea usted un médico veterinario en busca de diagnósticos confiables o un tutor preocupado por la salud de su mascota, brindamos información precisa y confiable para apoyar cada decisión clínica.

-
Estándares Rigurosos de Calidad
-
Tecnología de Vanguardia
-
Servicios Diagnósticos Especializados
Nosotros
Somos un laboratorio liderado por tecnólogos médicos de la Universidad de La Frontera, especialistas en Microbiología clínica Veterinaria. Estamos enfocados principalmente en Bacteriología y Micología aplicadas a la salud de animales de compañía. Nuestro compromiso es entregar a las clínicas veterinarias de Temuco y la región un servicio confiable, rápido y especializado en diagnósticos microbiológicos, contribuyendo a la detección precisa de patologías infecciosas y apoyando en la toma de decisiones clínicas.
Nos destacamos por ofrecer prestaciones como Gram directo e indirecto, urocultivos, cultivos con antibiograma y cultivos de hongos, entre otros, cubriendo un área poco desarrollada pero esencial para el bienestar animal.
-
Especialización en Microbiología Veterinaria
-
Apoyo directo a las Clínicas Veterinarias
-
Innovación y desarrollo local
Labivet
Prestaciones
Rama que estudia bacterias y otros microorganismos. Incluye cultivos para detectar infecciones bacterianas en diferentes muestras (orina, semen, flujo vaginal, deposiciones, etc.) y determinar si requieren tratamiento antibiótico.
-
Cultivo corriente
-
Flujo vaginal
-
Espermocultivo
-
Urocultivo
-
Coprocultivo
Exámenes que evalúan la orina, su composición química y microscópica, para diagnosticar enfermedades renales, urinarias o metabólicas.
-
Orina semicuantitativa
-
Orina completa (incluye sedimento)
Pruebas realizadas en heces para identificar parásitos intestinales, infecciones y alteraciones digestivas o inflamatorias.
-
Parasitológico seriado (PSD)
-
Leucocitos fecales
-
Directo de heces
Exámenes que detectan la presencia de hongos en piel, pelo, uñas, secreciones u otras muestras. Se utilizan especialmente para diagnosticar micosis o dermatofitosis en animales.
-
Directo de hongos
-
Cultivo de hongos / dermatofitos
Pruebas que detectan anticuerpos o antígenos en la sangre. Se usan para diagnosticar enfermedades virales frecuentes en animales de compañía (como leucemia felina, inmunodeficiencia felina, distemper y parvovirus).
-
FeLV (Leucemia felina)
-
FIV (Inmunodeficiencia felina)
-
Distemper
-
Parvovirus
Galería de Imágenes
Nuestro Laboratorio

Calidad certificada, trabajando junto a los principales referentes del rubro







